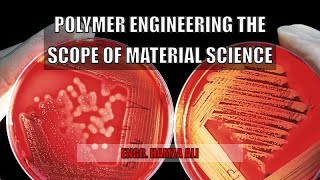

Shared 3 years ago
2.8K views
Shared 4 years ago
10K views
Maximize Polymer Performances Through Formulation Optimization Using (DMA) Dynamic Mechanical Analys
Shared 3 years ago
104 views
Shared 2 years ago
463 views
Shared 4 years ago
4.7K views
Shared 3 years ago
3.1K views
Shared 2 years ago
3.4K views
Shared 3 years ago
1.8K views
Silyl Modified Polymer-Based Adhesives: Innovations & Formulation Strategies For Optimal Performance
Shared 3 years ago
351 views
Shared 2 years ago
10K views
Shared 2 years ago
346 views
Shared 7 months ago
79 views
Shared 2 years ago
763 views
Shared 5 years ago
550 views
Shared 5 years ago
6.5K views
Shared 1 year ago
109 views
Shared 2 years ago
162 views
Shared 11 months ago
238 views
Shared 8 months ago
88 views
Shared 6 months ago
15 views
Shared 1 month ago
278 views
Shared 1 year ago
113 views